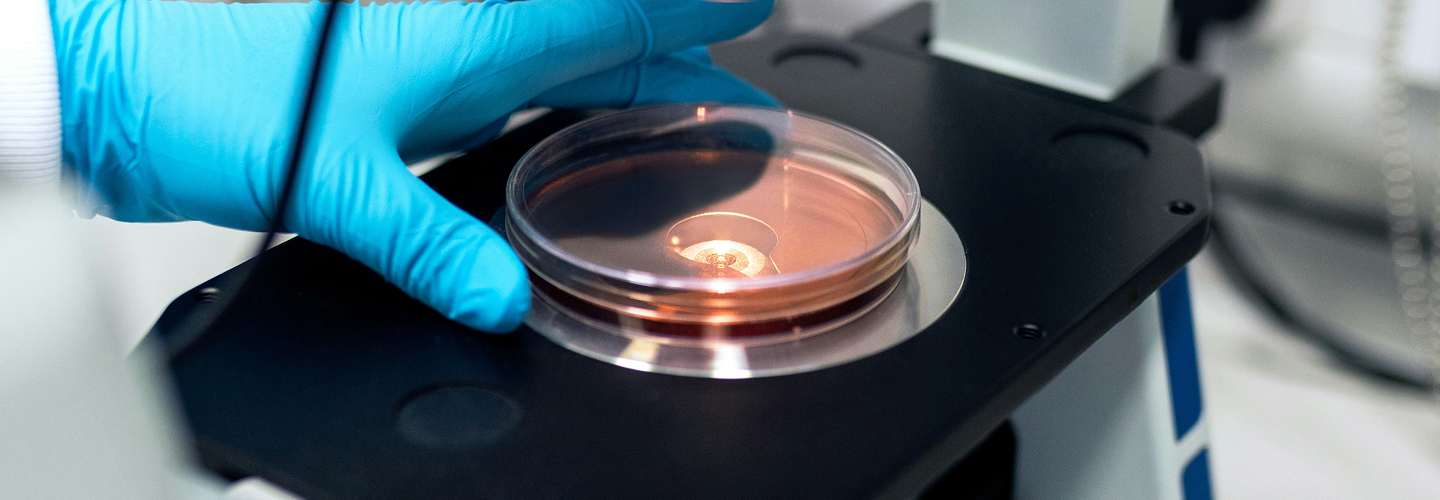
Dermascore – laboratoire

Derma Score repose sur une méthodologie scientifique indépendante permettant d’évaluer la sécurité et la qualité des cosmétiques avec précision. Chaque produit est examiné en profondeur : formulation, concentrations réelles, risques toxicologiques et conformité aux standards internationaux. Cette approche rigoureuse garantit une note claire de A+ à C, devenue un repère majeur pour les consommateurs à la recherche de produits fiables et sûrs.

Derma Score ne se limite pas aux mentions marketing. Chaque ingrédient est étudié selon :
-
sa concentration réelle ;
-
son potentiel irritant ou allergénique ;
-
son statut CMR ;
-
son impact en tant que perturbateur endocrinien.
Cette approche élimine les ambiguïtés souvent présentes dans les évaluations superficielles.
Des toxicologues certifiés réalisent une évaluation complète :
-
calcul de la marge de sécurité (MoS) ;
-
scénarios d’exposition réalistes ;
-
analyse des avis SCCS, CIR, NICNAS, NTP, IARC.
Le processus est neutre, indépendant et scientifiquement documenté.


Conformité aux standards internationaux
Derma Score intègre plus de 60 normes et référentiels internationaux, garantissant une évaluation cohérente, fiable et compatible avec les marchés européens, américains et asiatiques. Cette dimension mondiale assure une conformité aux réglementations les plus strictes et anticipe les évolutions futures du secteur cosmétique.
Une notation claire et compréhensible
La note Derma Score (A+ à C) simplifie la lecture des risques liés aux ingrédients. Elle fournit une information fiable, immédiatement accessible aux consommateurs et facile à valoriser pour les marques.
Contrôles annuels systématiques
Chaque année, Derma Score réalise :
-
un contrôle qualité aléatoire sur les produits labellisés ;
-
une mise à jour des données toxicologiques ;
-
une vérification de la conformité des formules.
Ces contrôles garantissent une transparence continue.

Pourquoi Derma Score s’impose comme référence
Grâce à son indépendance, son approche scientifique et sa transparence totale, Derma Score devient un label incontournable pour les cosmétiques, les produits bébé et la détergence. Pour les marques, il renforce la crédibilité et le référencement. Pour les consommateurs, il apporte une garantie claire, fiable et durable sur la sécurité des produits appliqués sur la peau.

